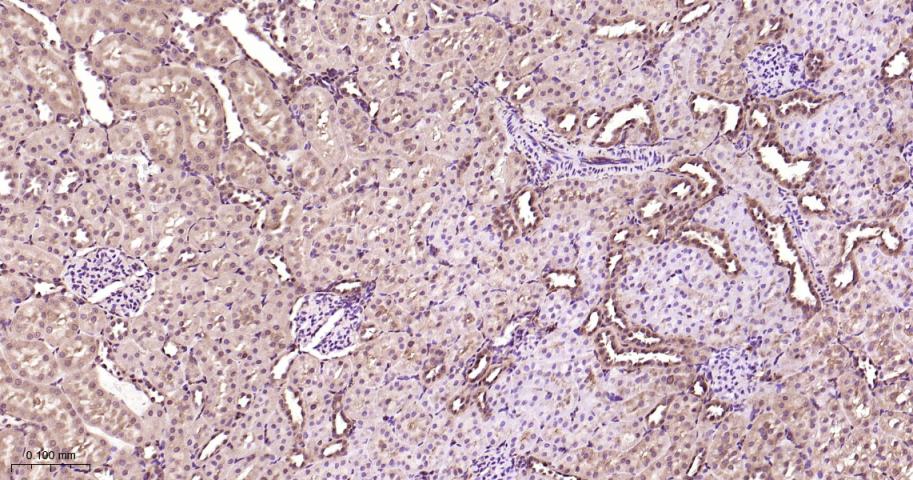
丝裂原活化蛋白激酶1/ERK 1/2重组兔单抗

ERK1/2 Recombinant Rabbit mAb (一抗) - WB,IHC-P,IHC-F,IF,Flow-Cyt,ICC/IF | Bioss
Rrmab?兔单抗

货号:bsm-52259R
产品详情
相关标记
相关产品
相关文献
常见问题
概述
产品编号
bsm-52259R
产品类型
重组兔单抗
英文名称
ERK1/2 Recombinant Rabbit mAb
中文名称
丝裂原活化蛋白激酶1/ERK 1/2重组兔单抗
英文别名
MK03_HUMAN; MAPK3; MAP kinase 3; MAPK 3; ERT2; Extracellular signal-regulated kinase 1 (ERK-1); Insulin-stimulated MAP2 kinase; MAP kinase isoform p44 (p44-MAPK); Microtubule-associated protein 2 kinase; p44-ERK1; 2.7.11.24; ERK1; PRKM3; MK01_HUMAN; MAPK1; MAP kinase 1; MAPK 1; ERT1; Extracellular signal-regulated kinase 2 (ERK-2); MAP kinase isoform p42 (p42-MAPK); Mitogen-activated protein kinase 2 (MAP kinase 2 | MAPK 2); ERK2; PRKM1; PRKM2; ERK; ERK-2; MAPK2; NS13; P42MAPK; p38; p40; p41; p41mapk; p42-MAPK; ERK-1; HS44KDAP; HUMKER1A; P44ERK1; P44MAPK; p44-MAPK; p44/42;
抗体来源
Rabbit
免疫原
KLH conjugated synthetic peptide derived from human ERK1/2
亚型
IgG
性状
Liquid
纯化方法
affinity purified by Protein A
克隆类型
Recombinant
克隆号
3A12
理论分子量
42/44 kDa
检测分子量
42/44 kDa
浓度
1mg/ml
储存液
0.01M TBS (pH7.4) with 1% BSA, 0.02% Proclin300 and 50% Glycerol.
研究领域
SWISS
Gene ID
保存条件
Store at -20℃ for one year. Avoid repeated freeze/thaw cycles.
注意事项
This product as supplied is intended for research use only, not for use in human, therapeutic or diagnostic applications.
数据库链接
产品介绍
激酶和磷酸酶(Kinases and Phosphatases)
丝裂原活化蛋白激酶-ERK1/2(Mitogen-activated protein kinase 1/2)是一组可以被多种细胞外信号即获得蛋白丝/苏氨酸激酶,处于胞浆信号传导通路的终末位置,活化后转位到核内,作用于核内转录因子,调节基因表达。它主要参与生长因子、激素、细胞因子、应激等各种刺激下细胞的反应、细胞的生长、分化过程.
丝裂原活化蛋白激酶-ERK1/2(Mitogen-activated protein kinase 1/2)是一组可以被多种细胞外信号即获得蛋白丝/苏氨酸激酶,处于胞浆信号传导通路的终末位置,活化后转位到核内,作用于核内转录因子,调节基因表达。它主要参与生长因子、激素、细胞因子、应激等各种刺激下细胞的反应、细胞的生长、分化过程.
背景资料
The protein encoded by this gene is a member of the MAPkinase family. MAP kinases, also known as extracellularsignal-regulated kinases (ERKs), act in a signaling cascade thatregulates various cellular processes such as proliferation,differentiation, and cell cycle progression in response to avariety of extracellular signals. This kinase is activated byupstream kinases, resulting in its translocation to the nucleuswhere it phosphorylates nuclear targets. Alternatively splicedtranscript variants encoding different protein isoforms have beendescribed. [provided by RefSeq, Jul 2008].

产品应用
| 应用 | 已检合格种属 | 预测种属 | 推荐稀释比例 |
|---|---|---|---|
| WB | Human, Mouse, Rat | 1:1000-5000 | |
| IHC-P | Human, Mouse, Rat | 1:200-800 | |
| IHC-F | Human, Mouse, Rat | 1:200-800 | |
| IF | Human, Mouse, Rat | 1:200-800 | |
| Flow-Cyt | Human | Mouse, Rat | 1ug/Test |
| ICC/IF | Human | Mouse, Rat | 1:100-500 |
交叉反应
交叉反应: Human, Mouse, Rat
相关产品
暂无相关产品
靶标
基因名
MAPK3
蛋白名
Mitogen-activated protein kinase 3
亚基
Binds both upstream activators and downstream substratesin multimolecular complexes. Interacts with ADAM15, ARHGEF2, ARRB2,DAPK1 (via death domain), HSF4, IER3, IPO7, DUSP6, NISCH, SGK1, andisoform 1 of NEK2. Interacts (via phosphorylated form) with TPR(via C-terminus region and phosphorylated form); the interactionrequires dimerization of MAPK1/ERK2 and increases following EGFstimulation. Interacts (phosphorylated form) withCAV2 ('Tyr-19'-phosphorylated form); the interaction, promoted byinsulin, leads to nuclear location and MAPK1 activation. Interacts with DCC. Interacts withMORG1, PEA15 and MKNK2. MKNK2 isoform 1 binding prevents fromdephosphorylation and inactivation. The phosphorylated forminteracts with PML.
亚细胞定位
Cytoplasm, cytoskeleton, spindle. Nucleus. Cytoplasm, cytoskeleton, centrosome. Cytoplasm. Note=Associated with the spindle duringprometaphase and metaphase. PEA15-binding andphosphorylated DAPK1 promote its cytoplasmic retention.Phosphorylation at Ser-244 and Ser-246 as well asautophosphorylation at Thr-188 promote nuclear localization.
组织特异性
Widely expressed.
翻译后修饰
Dually phosphorylated on Thr-183 and Tyr-185, which activatesthe enzyme. Ligand-activated ALK induces tyrosine phosphorylation. Dephosphorylated by PTPRJ at Tyr-185. Phosphorylated upon FLT3 and KIT signaling.
相似性
Belongs to the protein kinase superfamily. CMGCSer/Thr protein kinase family. MAP kinase subfamily.
Contains 1 protein kinase domain.
Contains 1 protein kinase domain.
功能
Serine/threonine kinase which acts as an essentialcomponent of the MAP kinase signal transduction pathway. MAPK1/ERK2and MAPK3/ERK1 are the 2 MAPKs which play an important role in theMAPK/ERK cascade. They participate also in a signaling cascadeinitiated by activated KIT and KITLG/SCF. Depending on the cellularcontext, the MAPK/ERK cascade mediates diverse biological functionssuch as cell growth, adhesion, survival and differentiation throughthe regulation of transcription, translation, cytoskeletalrearrangements. The MAPK/ERK cascade plays also a role ininitiation and regulation of meiosis, mitosis, and postmitoticfunctions in differentiated cells by phosphorylating a number oftranscription factors. About 160 substrates have already beendiscovered for ERKs. Many of these substrates are localized in thenucleus, and seem to participate in the regulation of transcriptionupon stimulation. However, other substrates are found in thecytosol as well as in other cellular organelles, and those areresponsible for processes such as translation, mitosis andapoptosis. Moreover, the MAPK/ERK cascade is also involved in theregulation of the endosomal dynamics, including lysosome processingand endosome cycling through the perinuclear recycling compartment(PNRC); as well as in the fragmentation of the Golgi apparatusduring mitosis. The substrates include transcription factors (suchas ATF2, BCL6, ELK1, ERF, FOS, HSF4 or SPZ1), cytoskeletal elements(such as CANX, CTTN, GJA1, MAP2, MAPT, PXN, SORBS3 or STMN1),regulators of apoptosis (such as BAD, BTG2, CASP9, DAPK1, IER3,MCL1 or PPARG), regulators of translation (such as EIF4EBP1) and avariety of other signaling-related molecules (like ARHGEF2, DCC,FRS2 or GRB10). Protein kinases (such as RAF1, RPS6KA1/RSK1,RPS6KA3/RSK2, RPS6KA2/RSK3, RPS6KA6/RSK4, SYK, MKNK1/MNK1,MKNK2/MNK2, RPS6KA5/MSK1, RPS6KA4/MSK2, MAPKAPK3 or MAPKAPK5) andphosphatases (such as DUSP1, DUSP4, DUSP6 or DUSP16) are othersubstrates which enable the propagation the MAPK/ERK signal toadditional cytosolic and nuclear targets, thereby extending thespecificity of the cascade. Mediates phosphorylation of TPR inrespons to EGF stimulation. May play a role in the spindle assemblycheckpoint. Phosphorylates PML and promotes its interaction withPIN1, leading to PML degradation (By similarity).
Acts as a transcriptional repressor. Binds to a[GC]AAA[GC] consensus sequence. Repress the expression ofinterferon gamma-induced genes. Seems to bind to the promoter ofCCL5, DMP1, IFIH1, IFITM1, IRF7, IRF9, LAMP3, OAS1, OAS2, OAS3 andSTAT1. Transcriptional activity is independent of kinase activity.
Acts as a transcriptional repressor. Binds to a[GC]AAA[GC] consensus sequence. Repress the expression ofinterferon gamma-induced genes. Seems to bind to the promoter ofCCL5, DMP1, IFIH1, IFITM1, IRF7, IRF9, LAMP3, OAS1, OAS2, OAS3 andSTAT1. Transcriptional activity is independent of kinase activity.
同靶标产品
相关文献
提示: 发表研究结果有使用 bsm-52259R 时请让我们知道,以便我们可以引用参考文章。作为回馈,资料提供者将获得我们送上的小礼品。
具体参考文献:bsm-52259R 被引用于11文献中